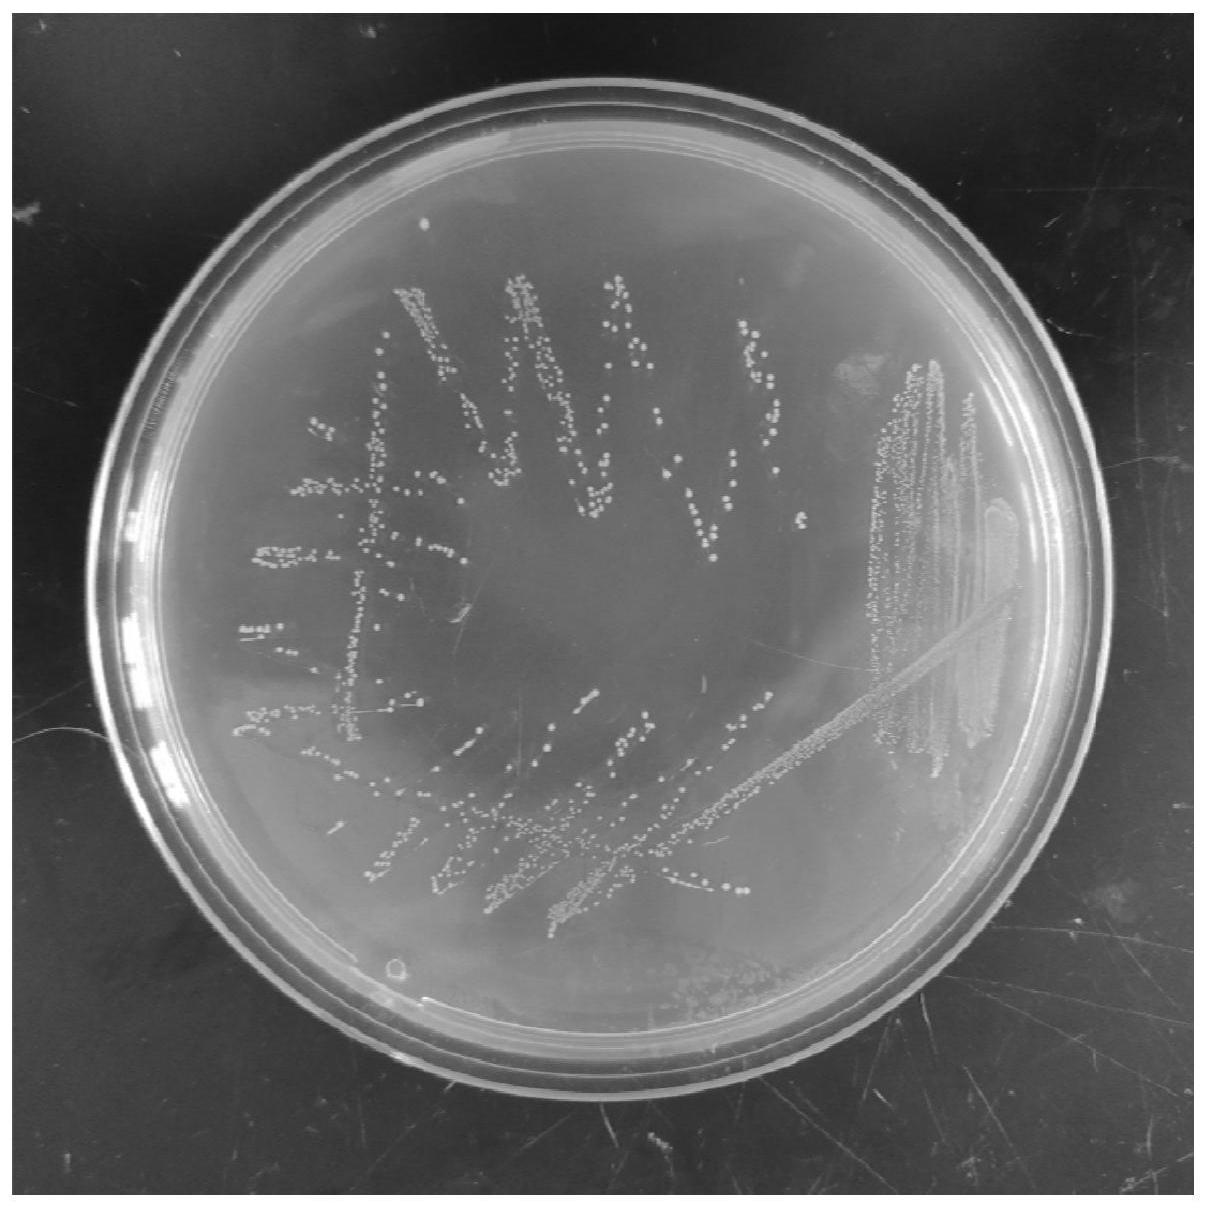
一株高产2壬酮的乳酸乳球菌乳酸亚种及其应用

乳球菌属

乳酸乳球菌乳亚种菌种传代
图片尺寸600x600
格氏乳球菌格氏亚种
图片尺寸1000x995
真菌细胞.这是乳酸乳球菌,常被用来制作奶酪.
图片尺寸516x600
柠檬色葡萄球菌…… a群链球菌 化脓链球菌 链球菌属 b群链球菌 无乳
图片尺寸1080x810
乳球菌属
图片尺寸268x201
cn105385640b_格氏乳球菌及其应用有效
图片尺寸1000x799
一株乳酸乳球菌乳酸亚种及其在制备豆乳中的应用的制作方法
图片尺寸926x927
一株格氏乳杆菌及其缓解和治疗高尿酸血症的用途的制作方法
图片尺寸1208x1158
一株冷水鱼益生菌乳酸乳球菌菌株及其用途制造技术
图片尺寸1000x433
微生物饲料的发酵方法
图片尺寸494x595
一株可改善口腔健康的乳酸乳球菌及其应用的制作方法
图片尺寸1000x453
一株高产2壬酮的乳酸乳球菌乳酸亚种及其应用
图片尺寸1207x1209
链球菌属嗜热链球菌,乳酸链球菌等.
图片尺寸632x380
cn109593668a_一株高产异戊醛的乳酸乳球菌乳酸亚种及其应用
图片尺寸1000x994
其实,这是因为售卖的酸奶菌种不少是保加利亚乳杆菌和嗜热链球菌,在40
图片尺寸640x427
乳酸乳球菌乳脂亚种1000亿冻干益生菌原菌粉粉肠道发酵乳现货
图片尺寸800x800
一株具有良好抗氧化活性的乳酸乳球菌霍氏亚种及其应用的制作方法
图片尺寸1000x972
p>乳酸菌(lactic acid bacteria,lab)是一类能利用可发酵碳水化合物
图片尺寸600x401
乳杆菌,双歧杆菌属,圆形,链球菌,益生菌
图片尺寸1100x1100
丙酸杆菌,嗜热链球菌下排从左到右:双歧杆菌,乳杆菌,乳球菌图片来源
图片尺寸1000x754